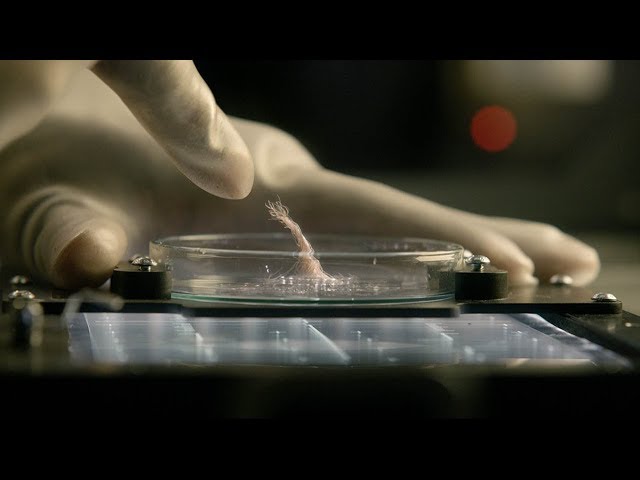

(You can now enjoy Offworld as a podcast: http://www.tested.com/offworld)
If astronauts ever discovered microbial life in space, what would be the procedures for studying it? That's one of the plot points of the 2017 science fiction film Life, which we discuss with Dr. Penny Boston, director of NASA's Astrobiology Institute. Let's talk through the ideas of biological containment onboard the ISS and how a Mars sample return would actually work.
Subscribe for more videos! http://www.youtube.com/subscription_c...
Follow us on Twitter: http://www.twitter.com/testedcom
Get updates on Facebook: http://www.facebook.com/testedcom
Tested is:
Adam Savage http://www.twitter.com/donttrythis
Norman Chan http://www.twitter.com/nchan
Simone Giertz http://www.twitter.com/simonegiertz
Joey Fameli http://www.joeyfameli.com
Gunther Kirsch https://guntherkirsch.com
Ryan Kiser https://www.instagram.com/ryan.kiser
Kishore Hari http://www.twitter.com/sciencequiche
Sean Charlesworth http://www.twitter.com/cworthdynamics
Jeremy Williams http://www.twitter.com/jerware
Kayte Sabicer https://twitter.com/kaytesabicer
Bill Doran https://twitter.com/chinbeard
Ariel Waldman http://www.twitter.com/arielwaldman
Darrell Maloney http://www.twitter.com/thebrokennerd83
Kristen Lomasney https://twitter.com/krystynlo
Intro bumper by Abe Dieckman
Set build by Asa Hillis http://www.asahillis.com
Set design by Danica Johnson http://www.twitter.com/saysdanica
Thanks for watching!
How Would A Mars Sample Return Work? - Offworld Episode 18 ─ Adam Savage’s Tested
<style>.embed-container { position: relative; padding-bottom: 56.25%; height: 0; overflow: hidden; max-width: 100%; } .embed-container iframe, .embed-container object, .embed-container embed { position: absolute; top: 0; left: 0; width: 100%; height: 100%; }</style><div class="embed-container"><iframe src="https://www.youtube.com/embed/FLC97Gh0BRM" frameborder="0" allowfullscreen></iframe></div>